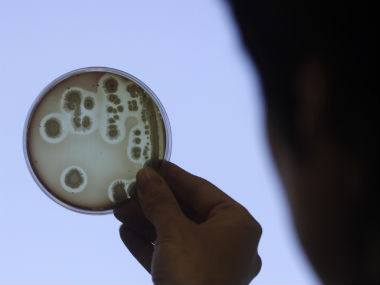
UCLA says more than 100 were exposed 'superbug' in California hospital UCLA says more than 100 were exposed 'superbug' in California hospital

Los Angeles: A potentially deadly “superbug” resistant to antibiotics infected seven patients, including two who died, and more than 100 others were exposed at a California hospital through contaminated medical instruments, UCLA reported Wednesday. Patients at Ronald Reagan UCLA Medical Center were exposed to CRE during endoscopic procedures between October and January, the University of California, Los Angeles said in a statement. It may have been a “contributing factor” in the deaths of two patients, the university said. Similar outbreaks of Carbapenem-Resistant Enterobacteriaceae (CRE) have been reported around the nation. They are difficult to treat because some varieties are resistant to most known antibiotics. By one estimate, CRE can contribute to death in up to half of seriously infected patients, according to the national Centers for Disease Control and Prevention. [caption id=“attachment_1693013” align=“alignleft” width=“380”] Representational Image. Reuters[/caption] The bacteria can cause infections of the bladder or lungs, leading to coughing, fever or chills. CRE infections have been reported in every state except Idaho, Alaska and Maine, according to the CDC. UCLA said infections may have been transmitted through endoscopes used during the diagnosis and treatment of pancreatic and bile-duct problems. The two medical devices may have carried the bacteria even though they were sterilized according to the manufacturer’s specifications, UCLA said. The devices have been removed, and decontamination procedures upgraded, the university said. Potentially infected patients are being sent free home-testing kits that UCLA will analyze, the university said. A similar outbreak occurred in Illinois in 2013. Dozens of patients were exposed to CRE, with some cases apparently linked to a tainted endoscope used at Advocate Lutheran General Hospital. The hospital later changed its sterilization procedures. A Seattle hospital, Virginia Mason Medical Center, reported in January that CRE linked to an endoscope sickened at least 35 patients, and 11 died, although it was unclear whether the infection played a role in their deaths. Associated Press
Representational Image. Reuters[/caption] The bacteria can cause infections of the bladder or lungs, leading to coughing, fever or chills. CRE infections have been reported in every state except Idaho, Alaska and Maine, according to the CDC. UCLA said infections may have been transmitted through endoscopes used during the diagnosis and treatment of pancreatic and bile-duct problems. The two medical devices may have carried the bacteria even though they were sterilized according to the manufacturer’s specifications, UCLA said. The devices have been removed, and decontamination procedures upgraded, the university said. Potentially infected patients are being sent free home-testing kits that UCLA will analyze, the university said. A similar outbreak occurred in Illinois in 2013. Dozens of patients were exposed to CRE, with some cases apparently linked to a tainted endoscope used at Advocate Lutheran General Hospital. The hospital later changed its sterilization procedures. A Seattle hospital, Virginia Mason Medical Center, reported in January that CRE linked to an endoscope sickened at least 35 patients, and 11 died, although it was unclear whether the infection played a role in their deaths. Associated Press
UCLA says more than 100 were exposed 'superbug' in California hospital
FP Archives
• February 19, 2015, 07:27:34 IST
A potentially deadly “superbug” resistant to antibiotics infected seven patients, including two who died, and more than 100 others were exposed at a California hospital.
Advertisement
)